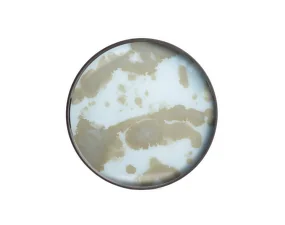
Podnos Organic Glass Tray Round S, mist gold

Menu
- Nábytok
- Policové systémy
- Svietidlá
- Doplnky
- Tapety
- Stolovanie
- Outdoor
- Zľavy
- Outlet
- Novinky
- Inšpirácia
-
Značky
Zavrieť
- &Tradition
- Artek
- Audo Copenhagen
- Bolia
- BorasTapeter
- Brokis
- Danlamp
- Design Letters
- Engblad & Co
- Ethnicraft
- Eva Solo
- Ferm Living
- Flexa
- Flos
- Fritz Hansen
- GUBI
- HAY
- Iittala
- Lind DNA
- Louis Poulsen
- Muuto
- New Works
- Nichba
- Nofred
- Noo.ma
- Normann Copenhagen
- Norr11
- Northern
- Nuura
- Oblure
- Pholc
- Rig-Tig
- Sandberg
- Skagerak
- Stelton
- String Furniture
- The Poster Club
- Verpan
- Vitra
- 101 Copenhagen
- 24Bottles